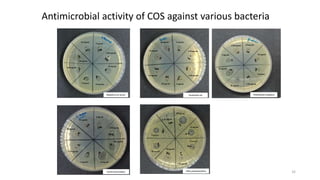
Staphylococcus aureus
20 mg/mL
20 mg/mL
10 mg/mL
5 mg/mL
2.50 mg/mL
10 mg/mL
5 mg/mL
2.50 mg/mL
Escherichia coli
20 mg/mL
10 mg/mL 5 mg/mL
2.50 mg/mL
20 mg/mL
10 mg/mL 5 mg/mL
2.50 mg/mL
Pseudomonas aeruginosa
20 mg/mL
10 mg/mL
5 mg/mL
2.50 mg/mL 20 mg/mL
10 mg/mL
5 mg/mL
2.50 mg/mL
Vibrio parahaemolyticus
20 mg/mL
10 mg/mL
5 mg/mL
2.50 mg/mL
20 mg/mL
10 mg/mL
5 mg/mL
2.50 mg/mL
20 mg/mL
10 mg/mL
5 mg/mL
2.50 mg/mL
200 mg/mL
10 mg/mL
5 mg/mL
2.50 mg/mL
Listeria monocytogens
Antimicrobial activity of COS against various bacteria
32

This document discusses chitin, chitosan, and chitooligosaccharides derived from fishery waste. It begins by describing the different sources and structures of chitin. The document then outlines the processes for extracting and producing chitin, chitosan, and chitooligosaccharides from crustacean shells. These include demineralization, deproteinization, and deacetylation. The document discusses characterizing and analyzing these compounds and provides examples of their properties and applications as flocculants, fat binders, films, coatings, and antimicrobial agents.












![Yield, degree of deacetylation (DDA), intrinsic viscosity, and viscosity-average molecular weight
of chitosan from squid pen chitin deacetylated under different temperatures and times
Temperature
(°C)
Extraction time
(hr)
Yield (%) DDA (%) [η] (dL/g) MW (Da)
110
2 64.99 ± 1.83aA 78.21 ± 1.28eC 6.52 ± 0.02aA 3.2 × 105
4 54.12 ± 1.67bB 84.65 ± 0.42dB 4.19 ± 0.04bB 1.7 × 105
8 50.54 ± 0.80cC 86.84 ± 0.4cA 3.47 ± 0.02dC 1.3 × 105
130
2 53.51 ± 1.22dA 86.55 ± 0.73cC 3.79 ± 0.02cA 1.5 × 105
4 51.91 ± 1.21bcB 87.74 ± 0.49bA 3.39 ± 0.08eB 1.3 × 105
8 50.07 ± 1.02cB 89.72 ± 0.37aB 3.24 ± 0.02fC 1.2 × 105
Singh, A., Benjakul, S., & Prodpran, T. (2019). Ultrasound‐assisted extraction of chitosan from squid pen: Molecular characterization and fat binding capacity. Journal of food
science, 84(2), 224-234. 13](https://image.slidesharecdn.com/chitinchitosanandcos-230204084221-2c16d48b/85/Chitin-chitosan-and-COS-pptx-13-320.jpg)